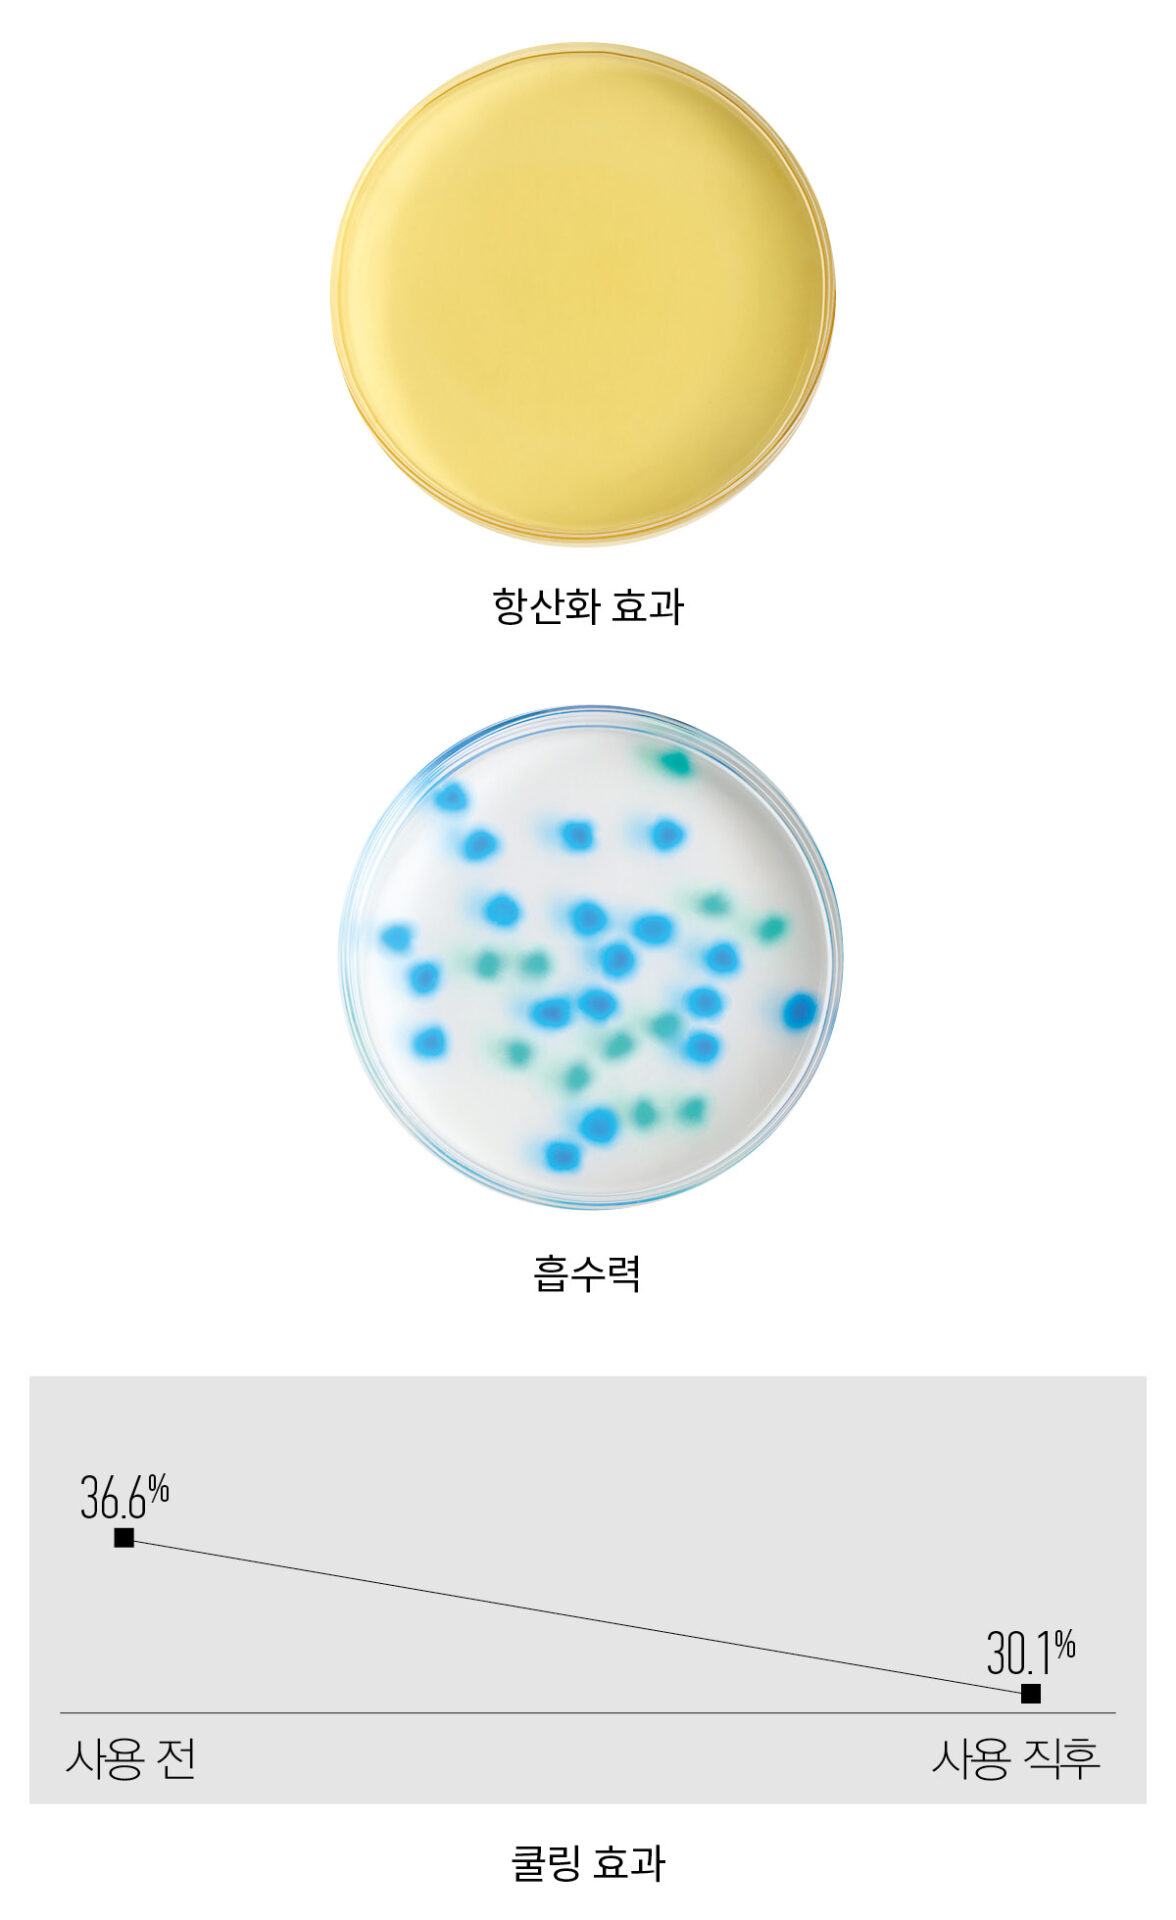
록시땅 퓨리파잉 프레시니스 샤인 비니거

두피 문제 단속반 헤어 토닉의 진화
두피 위로 떠오른 문제를 단숨에 진화할 SOS 헤어 토닉.

얼굴에 열이 오르면 쿨링 미스트를 뿌리고, 차가운 물건을 찾아 뺨에 대어 열을 식히곤 한다. 하지만 두피는? 그냥 열이 오르면 오르는 대로 속수무책인 것처럼 대한다. 열뿐 아니라 각종 자극에서도 그렇다. 아무것도 하지 않는 동안에도 두피는 각종 스트레스와 외부 자극으로부터 손상을 입는다. 얼굴 피부처럼 눈에 보이지는 않지만 이런 손상은 두피에 차곡차곡 쌓인다. 2년여간 탈색과 염색을 반복하던 에디터도 그랬다. 리페어 샴푸와 헤어트리트먼트, 오일까지 꾸준히 챙겼지만 정작 두피에는 어떤 관리도 하지 않았다. 언젠가부터 평소 화끈거리는 느낌에 그치던 두피가 빨갛게 변했고, 급기야 터진 두피에서 진물이 나며 상처가 생겼다. 그때 찾게 된 것이 헤어 토닉인데, 그 필요성에 대해 자신 있게 말할 수 있을 정도로 두피 컨디션 변화를 확실하게 경험했다. 단순히 에디터 개인에 국한된 이야기가 아니다. 지난해 올리브영 헤어 케어 제품 중 토닉과 앰플 등이 포함된 ‘스페셜 케어’ 카테고리 매출이 1년 만에 151% 상승했다. 많은 이들이 두피 문제에 눈을 뜨고, 케어의 중요성을 인지하고 있다는 것. 이런 변화에 편승한 브랜드에서는 효능이 좋아진 두피 케어 아이템을 발 빠르게 출시했다. 그중 가장 눈에 띄는 것은 단연 헤어 토닉. 간편하게 뿌려 사용함으로써 양 조절이 어렵지 않아 모발이 떡 질 일이 없다. “두피도 피부이기 때문에 자극을 주는 성분을 배제하고 두피가 편안함을 느끼도록 천연 유래 진정 성분을 추가했어요.” 레브론 프로페셔널 마케팅 담당자 황지현 대리의 설명이다. 록시땅 브랜드 교육팀 권은지 매니저의 설명도 헤어 토닉의 발전을 실감하게 한다. “과거의 헤어 토닉은 알코올과 화학물질이 주성분을 이뤘습니다. 최근에는 천연 성분을 이용해 자극을 줄이고 두피 건강을 촉진하죠.” 두피도 피부라는 것을 우리는 자주 잊는다. 소 잃고 외양간 고친들 소가 돌아오리라는 보장은 없지만, 탄탄한 울타리를 만들면 소를 잃어버릴 일조차 없다는 것을 잊지 말자. 그리고 그 울타리를 탄탄하게 하는 데 헤어 토닉만 한 아이템이 없다는 사실도.
SCALP TONIC LABORATORY
두피에 쌓인 자극을 지우고 영양을 듬뿍 채워줄 헤어 토닉을 <뷰티쁠> 실험실에서 비교했다.
LAB #1 항산화 효과
방법 갈색 요오드 용액에 제품을 녹인 뒤 색 변화를 관찰한다. 기존 제형의 색으로 돌아올수록 항산화 효과가 뛰어나다고 본다.
LAB #2 흡수력
방법 건조한 상태의 워터비즈에 동일한 양의 제품을 섞은 물을 붓고 10분이 지난 후 알갱이의 크기 변화를 비교한다.
LAB #3 쿨링 효과
방법 제품을 사용한 뒤 두피 온도 변화를 측정한다.


#파워부스팅토닉
아베다 인바티 울트라 어드밴스드™ 리바이탈라이징 스칼프 세럼 150ml 9만5000원. 식물 활성 성분 1000여 가지 중 엄선한 식물 성분 3가지를 배합했다. 항산화 성분이 모발 깊이 스며든다.
LAB #1 ★★★★★ 제형의 컬러가 조금 남았을 뿐 가장 맑아졌다.
LAB #2 ★★★☆☆ 비즈가 제형을 흡수해 조금 커졌다.
LAB #3 ★★★☆☆


#SOS노세범토닉
저스트에즈아이엠 아이엠 토닉 N3 인텐시브 스칼프 케어 100ml 2만8000원. 피부 구조와 모발을 강화하는 성분이 두피 환경을 개선한다. 신선한 허브 향으로 두피 냄새를 잡아준다.
LAB #1 ★★★★☆ 노란 기가 빠르게 걷혔다.
LAB #2 ★★★★☆ 비즈가 통통한 느낌으로 부풀었다.
LAB #3 ★★☆☆☆


#마린에너지토닉
레브론 프로페셔널 익스피리언스 안티헤어로스 리바이탈라이징 토닉 125ml 4만7000원. 브랜드만의 테크놀로지를 적용해 진귀한 해양 성분의 효능을 극대화하고, 두피 본연의 힘을 키운다.
LAB #1 ★★★★☆ 노란빛이 아주 살짝 감돌았다.
LAB #2 ★★★★☆ 비즈의 표면이 투명해질 정도로 커졌다.
LAB #3 ★★★☆☆


#마이크로바이옴토닉
다비네스 에너자이징 씨크닝 토닉 100ml 7만5000원. 카페인 추출 성분이 두피 세포의 신진대사를 촉진한다. 외부 자극에도 최적화한 두피 밸런스를 유지하도록 돕는다.
LAB #1 ★★★★★ 노란 기가 거의 남지 않았다.
LAB #2 ★★★★☆ 제형이 빠르게 흡수되어 크기가 상당히 커졌다.
LAB #3 ★★★★☆


#5IN1토닉
트리셀 나이트 퍼펙터 100ml 3만5000원. 극한의 환경인 히말라야에서 자라 강인한 생명력을 지닌 티트리를 50% 담아 붉은 기를 잠재운다.
LAB #1 ★★★☆☆ 시간이 지났지만 노란빛이 다소 남았다.
LAB #2 ★★☆☆☆ 비즈가 커졌으나 변화의 폭이 가장 작았다.
LAB #3 ★★★★☆

#페퍼민트토닉
록시땅 퓨리파잉 프레시니스 샤인 비니거 100ml 3만9000원. 프로방스산 페퍼민트 오일이 두피를 빠르게 식힌다. 산뜻한 사용감으로 모발에 윤기를 더해준다.
LAB #1 ★★★★☆ 은은한 노란빛만 남았다.
LAB #2 ★★★★★ 건조한 상태의 비즈와 크기 차이가 가장 크게 났다.
LAB #3 ★★★★★
사진 김태선,오민지
모델 스완
메이크업&헤어 정지은
스타일리스트 박이화
도움말 권은지(록시땅 브랜드 교육팀), 황지현(레브론 프로페셔널 마케팅팀)
어시스턴트 박지현
